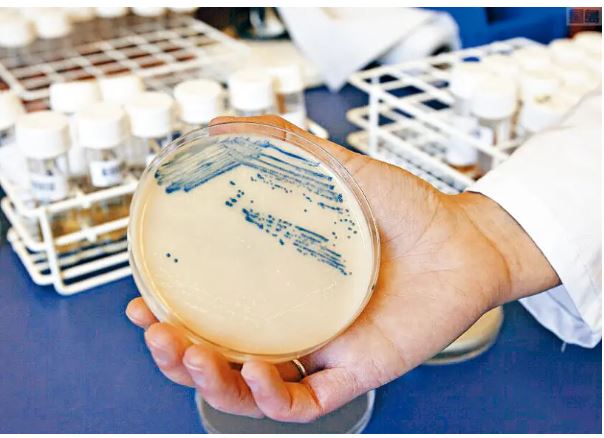
CDC曝 冠病疫情间 美「超级细菌」感染死亡激增

CDC曝冠病疫情间 美“超级细菌”感染死亡激增

(华盛顿14日综合电) 美国疾病控制与预防中心(CDC)日前发布最新报告指出,冠病疫情导致美国“超级细菌”(superbug)感染及死亡数激增,抵销了对抗“抗药性细菌”的多年进展。负责官员斯里尼瓦桑更直言,一些患者从冠病感染康复后,却面临死于抗药性感染的“恐怖后果”。
美国《国会山报》报道,据CDC最新分析报告,“超级细菌”的传染威胁不仅依然存在,而且有扩大趋势。
ADVERTISEMENT
CDC主任瓦伦斯基在报告中写道,2012至2017年,由于公卫单位的努力,美国医院内发生的抗药性感染降低将近30%,但在2020年,多种严重病原体的感染及死亡都比前一年激增15%,其中一种特别危险的抗药性细菌,会导致血液及尿液感染,病例数更在一年内飙升78%。
报告解释,冠病疫情刚爆发时,还有许多临床医师不熟悉新疾病,因此高度依赖抗生素,治疗发烧及呼吸急促的患者,而这些正是冠病症状。2020年3至10月,近80%冠病住院患者都曾接受抗生素治疗,但这些药物是专门对抗细菌、而非病毒,如此高强度的抗生素用药,反而把患者置于副作用的风险之中,也让具抗药性的细菌进一步发展及传播。
此外,冠病重症患者需要更长期、更频繁地使用医疗设施,例如导管及呼吸器,若医疗设施导致人体自然防护罩“皮肤”出现破口,也会增加感染风险。
报告指出,疫情期间,各地医院面临人员及个人防护设备的短缺,医护不堪重负,难以确实遵循预防及控制感染的规范,更有大量人力被调离感染预防及控制部门,以支援冠病照护。这形成了双重打击,也就是说,负责预防感染的人力更少了,却必须收治更多高风险患者。
负责监控超级细菌的CDC官员斯里尼瓦桑指出,冠病疫情对美国的病患安全造成深远影响,其中一个连锁效应就是抗药性感染,“这是一种很难治疗的感染,在一些案例中甚至是无法治疗的,死亡率非常高。”
2020年,美国有超过2万9400人死于与医疗照护有关的抗药性细菌感染。而在这些死亡病例中,将近40%是在住院期间被感染。由于疫情阻碍了部分数据分析,感染抗药物细菌的实际死亡率可能超出目前分析数据。
《华盛顿邮报》报道,抗药性感染之所以发生,是因为细菌持续演化,以利抵御杀死它们的药物,但随著突变,一些细菌发展出对抗不同抗生素的能力,并在此过程中,透过增殖把抗药性传下去。在这种情况下,越是使用抗生素,效果只会更差。
ADVERTISEMENT
热门新闻





百格视频





ADVERTISEMENT
































